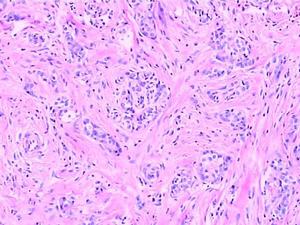
石蠟切片

實際套用
教學中,光鏡下觀察切片標本多數是石蠟切片法製備的。活的細胞或組織多為無色透明,各種組織間和細胞內各種結構之間均缺乏反差,在一般光鏡下不易清楚區別出;組織離開機體後很快就會死亡和產生組織腐敗,失去原有正常結構,因此,組織要經固定、石蠟包埋、切片及染色等步驟以免細胞組織死亡,而能清晰辨認其形態結構。
製作技術
石蠟切片法包括取材、固定、洗滌和脫水、透明、浸蠟、包埋、切片與粘片、脫蠟、染色、脫水、透明、封片等步驟。一般的組織從取材固定到封片製成玻片標本需要數日,但標本可以長期保存使用,為永久性顯微玻片標本。 石蠟切片
石蠟切片1.取材
應根據要求選取材料來源及部位。例如植物細胞有絲分裂多選取洋蔥根尖,細胞分裂快又便於切取;豬的肝小葉邊界清晰明確;耳蝸以豚鼠的內耳易於定位和剝離。材料必須新鮮,擱置時間過久則產生蛋白質分解變性,導致細胞自溶及細菌的滋生,而不能反映組織活體時的形態結構。
2.固定
用適當的化學藥液——固定液浸漬切成小塊的新鮮材料,迅速凝固或沉澱細胞和組織中的物質成分、終止細胞的一切代謝過程、防止細胞自溶或組織變化,儘可能保持其活體時的結構。固定能使組織硬化,有利於切片的進行,而且也有媒浸作用,有利於組織著色。固定液的種類很多,其對組織的硬化收縮程度以及組織內蛋白質、脂肪、糖類等物質的作用各不相同。例如純酒精可固定肝糖而能溶解脂肪,甲醛能固定一般組織,但溶解肝糖和色素。固定液可分為單一固定液及混合固定液。前者有甲醛(蟻醛、福馬林)、酒精、醋酸或冰醋酸、升汞、鋨酸(四氧化鋨)、重鉻酸鉀及苦味酸等,單一固定液不能固定細胞中的所有成分;混合固定液可以互補不足,常用的混合固定液有Bouin氏液、Zenker氏液、FAA液、Carnoy氏液、SuSa液(配方見有關技術書籍)。因此,應根據所要顯示的內容來選擇適宜的固定液。10%福馬林(4%甲醛)或10%磷酸緩衝福馬林是病理切片常規使用的固定液,不僅適用於常規HE(蘇木精-伊紅)染色,還可以用於組織學有關的其他技術的切片染色。固定液的用量通常為材料塊的20倍左右,固定時間則根據材料塊的大小及松密程度以及固定液的穿透速度而定,可以從1小時至數天,通常為數小時至24小時。
3.洗滌與脫水
固定後的組織材料需除去留在組織內的固定液及其結晶沉澱,否則會影響以後的染色效果。多數用流水沖洗;使用含有苦味酸的固定液固定的則需用酒精多次浸洗;如果組織經酒精或酒精混合液固定,則不必洗滌,可直接進行脫水。固定後或洗滌後的組織內充滿水分,如不除去水分就無法進行以後的透明、浸蠟與包埋,因為透明劑多數是苯類,苯類和石蠟均不能與水相融合,水分不脫盡,苯類不能浸入。酒精為常用脫水劑,它既能與水相混合,又能與透明劑相混,為了減少組織材料的急劇收縮,應使用從低濃度到高濃度遞增的順序進行,通常從30%或50%酒精開始,經70%、85%、95%直至純酒精(無水乙醇),每次時間為1~數小時,如不能及時進行各級脫水,材料可以放在70%酒精中保存,因高濃度酒精易使組織收縮硬化,不宜處理過久。正丁醇、叔丁醇、丙酮及二氧陸環等也可做脫水劑。
4.透明
純酒精不能與石蠟相溶,還需用能與酒精和石蠟相溶的媒浸液,替換出組織內的酒精。材料塊在這類媒浸液中浸漬,出現透明狀態,此液即稱透明劑,透明劑浸漬過程稱透明。常用的透明劑有二甲苯、苯、氯仿、正丁醇等,各種透明劑均是石蠟的溶劑。通常組織先經純酒精和透明劑各半的混合液浸漬1~2小時,再轉入純透明劑中浸漬。透明劑的浸漬時間則要根據組織材料塊大小及屬於囊腔抑或實質器官而定。如果透明時間過短,則透明不徹底,石蠟難於浸入組織;透明時間過長,則組織硬化變脆,就不易切出完整切片,最長為數小時。
5.浸蠟與包埋
用石蠟取代透明劑,使石蠟浸入組織而起支持作用。通常先把組織材料塊放在熔化的石蠟和二甲苯的等量混合液浸漬1~2小時,再先後移入2個熔化的石蠟液中浸漬3小時左右,浸蠟應在高於石蠟熔點3℃左右的溫箱中進行,以利石蠟浸入組織內。浸蠟後的組織材料塊放在裝有蠟液的容器中(擺好在蠟中的位置),待蠟液表層凝固即迅速放入冷水中冷卻,即做成含有組織塊的蠟塊。容器可用光亮且厚的紙摺疊成紙盒或金屬包埋框盒。如果包埋的組織塊數量多,應進行編號,以免差錯。石蠟熔化後應在蠟箱內過濾後使用,以免因含雜質而影響切片質量,且可能損傷切片刀。通常石蠟採用熔點為56~58℃或60~62℃兩種,可根據季節及操作環境溫度來選用。
6.切片
包埋好的蠟塊用刀片修成規整的方形或長方形,以少許熱蠟液將其底部迅速貼附於小木塊上,夾在輪轉式切片機(手動:精確而經濟的切片、半自動:機械化的穩定性和手動的手輪操作、全自動:快速準確輕鬆地進行臨床切片) 的蠟塊鉗內,使蠟塊切面與切片刀刃平行,鏇緊。切片刀的銳利與否、蠟塊硬度適當都直接影響切片質量,可用熱水或冷水等方法適當改變蠟塊硬度。通常切片厚度為4~7微米,切出一片接一片的蠟帶,用毛筆輕托輕放在紙上。
7.貼片與烤片
用粘附劑將展平的蠟片牢附於載玻片上,以免在以後的脫蠟、水化及染色等步驟中二者滑脫開。粘附劑是蛋白甘油。首先在潔淨的載玻片上塗抹薄層蛋白甘油,再將一定長度蠟帶(連續切片)或用刀片斷開成單個蠟片於溫水(45℃左右)中展平後,撈至玻片上鋪正,或直接滴兩滴蒸餾水於載玻片上,再把蠟片放於水滴上,略加溫使蠟片鋪展,最後用濾紙吸除多餘水分,將載玻片放入45℃溫箱中乾燥,也可在37℃溫箱中乾燥,但需適當延長時間。
8.切片脫蠟及水化
乾燥後的切片需脫蠟及水化才能在水溶性染液中進行染色。用二甲苯脫蠟,再逐級經純酒精及梯度酒精直至蒸餾水。如果染料配製於酒精中,則將切片移至與酒精近似濃度時,即可染色。
9.染色
染色的目的是使細胞組織內的不同結構呈現不同的顏色以便於觀察。未經染色的細胞組織其折光率相似,不易辨認。經染色可顯示細胞內不同的細胞器及內含物以及不同類型的細胞組織。染色劑種類繁多,應根據觀察要求及研究內容採用不同的染色劑及染色方法,還要注意選用適宜的固定劑才能取得滿意的結果。經典的蘇木精(Hematoxylin)和伊紅(曙紅,Eosin)染色法是組織學標本及病理切片標本的常規染色,簡稱HE染色。經HE染色後,細胞核被蘇木精染成紫藍色,多數細胞質及非細胞成分被伊紅染成粉紅色。由於蘇木精是帶陽離子的染料,染液呈鹼性,核內染色質及胞質核心糖體等物質對這種染料有親和性,稱嗜鹼性;而帶陰離子的染料伊紅配製的染液呈酸性,對這種染料的親和性,稱嗜酸性。有時不同的組織結構還需要用特殊的染料及染色方法加以顯示,稱特殊染色。有些細胞組織經硝酸銀浸潤後,可使溶液中銀離子還原成金屬銀或銀粒附著在細胞組織上,呈棕黑色,這種性質稱親銀性,而有些細胞組織本身不能使硝酸銀的銀離子還原成金屬銀,還需加還原劑才能將銀離子還原,稱嗜銀性。
10.切片脫水、透明和封片
染色後的切片尚不能在顯微鏡下觀察,需經梯度酒精脫水,在95%及純酒精中的時間可適當加長以保證脫水徹底;如染液為酒精配製,則應縮短在酒精中的時間,以免脫色。二甲苯透明後,迅速擦去材料周圍多餘液體,滴加適量(1~2滴)中性樹膠,再將潔淨蓋玻片傾斜放下,以免出現氣泡,封片後即製成永久性玻片標本,在光鏡下可長期反覆觀察。注意有些染料需特定廠家生產的產品。根據各種染色方法、組織類別及切片厚度,掌握適宜的染色時間,才能達到較好的染色效果。
石蠟製片程式及環節繁多,需數日才能完成1個周期,但切片可長期保存,供教學、科研及病理診斷及復察,並可利用蠟塊作其他項目的回顧性研究。病理常規製片過程中已簡化了一些細的環節或縮短了部分處理時間以適應臨床需要(可縮短至2天)。雖然冰凍切片大大快於石蠟切片,但所顯示的形態結構卻不如前者,因此病理醫生最後還需要根據石蠟切片作出準確診斷。近些年來,在病理常規製片過程中採用了微波技術,從而大大縮短了製片過程,而且對形態結構並沒有影響。微波是一種波長很短、頻率卻很高的高頻電磁波[波長為1米 ~1毫米,頻率為300兆赫(MHz)~300千兆赫(GHz)]。組織經微波輻射後加速組織內部分子的高速運動,以使液體的運輸加快,增加彌散、滲透和交換效率,從而加速組織的固定、脫水、透明、包埋和染色各個環節。例如常規福馬林固定需數小時~1天,而且能引起組織收縮及某些抗原成分不同程度的受到破壞,微波固定僅需1~2分鐘,且可減少抗原的丟失和損害。選擇適當的檔次(功率)、輻射時間和溫度是極為重要的。目前微波技術的套用在國內尚處於起步階段,許多技術套用環節尚需進一步摸索。
石蠟切片與其他技術方法的結合
石蠟切片雖然是經典的方法,但又是最基本的方法,它與其他新的技術方法相結合,使傳統的老技術擴大了其套用範圍,開闢了許多新領域,增加了許多新的研究、觀察內容。隨新的儀器及新的研究技術的不斷問世及使用,使組織學的觀察研究從簡單的形態結構深入到各種成分的定性觀察,又從定性轉向定量計測,使細胞組織的形態,功能及代謝三結合,從而達到定性可靠、定位準確及定量可測。
與免疫學技術結合 組織製片技術與免疫學技術結合構成免疫組織(細胞)化學技術,利用抗原與抗體的特異性結合原理,檢測組織切片中細胞組織的多肽及蛋白質等大分子物質的定性和定位觀察研究。不論哪種免疫組織化學技術都包括抗體的製備、組織材料處理、製備玻片標本以及免疫染色。冰凍切片手續簡便,製片過程中抗原活性丟失少,但組織細胞形態較差;石蠟切片步驟繁多,製片中抗原活性有所減低,但組織細胞形態清晰,是免疫組織化學常規製備切片方法之一。一般石蠟包埋的組織切片用於檢測胞漿或核內的抗原,不宜做表面抗原染色,有人將新鮮組織浸泡於冷磷酸緩衝液內48小時,再固定於96%乙醇或其他固定液固定的組織切片,可用於表面抗原染色。乙醇、丙酮等固定劑對抗原破壞較輕,但結構保存較差。最常用的固定液有中性和緩衝福馬林,它可與蛋白質交叉結合封閉抗原,在進行免疫染色前,切片再用蛋白酶消化,以暴露抗原部位、增強抗原的反應。在石蠟切片上進行的常用的免疫組化染色有免疫酶組織化學技術中的PAP法(非標記過氧化物酶-抗過氧化物酶法)及親和免疫組織化學技術中的ABC法(抗生物素-生物素-過氧化物酶複合物技術),其特異性強、敏感性高。使用兩種染色法的組織切片都需先經第一抗體(各種抗血清)孵育;再經第二抗體或生物素標記的第二抗體孵育;後經PAP復和物或ABC複合物孵育,最後以DAB(二氨基聯苯胺)-H2O2液顯色呈棕黃色沉澱。常規復染、脫水、透明、封片成永久性玻片標本,光鏡下檢測常規或特殊染色法難以顯示的成分及其精確定位,可用於基礎研究及臨床病理研究及診斷。微波用於石蠟包埋切片免疫組織化學染色既簡化步驟又節省時間,且能促進免疫染色效果。
石蠟包埋組織流式細胞儀DNA含量分析 是石蠟包埋組織切片與流式細胞術(flow cytometry,FCM)結合使用來測量DNA含量及倍體分析,這一結合是流式細胞儀在臨床套用中,特別是在腫瘤研究方面開拓了新的研究途徑。FCM是雷射、電子和電子計算機、流體噴射技術的綜合發展套用,是快速定量分析細胞的技術,要求被檢細胞呈懸浮狀態。目前已可測量細胞的大小、體積、DNA含量、DNA合成速率、RNA含量、表面抗原、染色體等。由於製備樣品技術的原因,過去許多流式分析資料僅限於採用新鮮組織標本,hedley等1983年首先報導了FCM分析石蠟包埋組織切片製備分散細胞懸液技術來進行DNA含量的檢測,從組織切片中能獲得足夠數量的單個細胞,且與新鮮組織分離獲得的單個細胞在形態及DNA含量組方圖上均極為相似。目前國內也在逐步開展這方面的研究。由於這種方法取材可在病理組織觀察或診斷基礎上進行,比活檢或手術切除標本更為準確,又可做回顧性研究分析;且對DNA檢測速度快、數據客觀可靠,在腫瘤診斷、預後的預測和治療反應上具有重要價值;利用過去的標本可成批製作細胞懸液、成批上機測試,避免了儀器調試狀態不同帶來的影響,石蠟包埋塊保存時間的長短對結果影響不大。
常規固定(多數用福馬林)、石蠟包埋的組織塊均可用於流式細胞術,但含苦味酸或汞的固定液均不宜使用。切片厚度以30~50微米為宜。切片脫蠟要乾淨、徹底,否則製備出的細胞懸液中碎片多,影響測定。梯度酒精水化後用胃蛋白酶或胰蛋白酶消化,消化後鏡檢呈單個分散狀態;由於福馬林固定可使DNA和核蛋白產生共價交聯,影響DNA和染料的化學定量結合,導致螢光強度下降,蛋白酶可破壞其聯結,改善測定的組方圖質量,消化時間以能分散細胞及細胞碎片儘量少為適度,以100目尼龍篩網濾去未消化完的組織片,離心去上清液後,加入冰冷的70%酒精固定,放入4℃冰櫃備用。上機前染色。DNA特異螢光染料主要有:(1)碘化丙錠(PI);(2)溴化乙錠(EB);(3) 4,6-二脒基-二苯基吲哚(DAPI)。FCM檢測石蠟包埋組織細胞DNA含量可做為以形態學為基礎,多參數綜合診斷中的一個重要的新手段。由於儀器設備價格昂貴及製備樣品的諸多環節均可能影響測定的數據,限制了臨床的廣泛使用。
石蠟切片標本是形態計量技術的基礎 形態計量技術是近年發展起來的一種新的定量檢測技術,用全自動圖像分析儀對組織和細胞內各種有形成分的數量、體積、長度及表面積等的圖像數據進行數學處理,以便對生物組織細胞及其結構成分的形態進行定量分析,如線粒體個數、內質網、細胞核及胞質面積、胰島的數量及各類細胞的數值、腎小體的數量和體積比以及Feulgen染色測定細胞核DNA原位定量等,使組織學及細胞學的研究由形態及定性觀察轉向形態定量化。形態計量是從石蠟組織切片或塗片以及組織的光鏡照片和電鏡照片上的各種結構獲取二維圖像數據,通過軟體程式處理,得出有價值的結構參數。這種數據準確性高、客觀性強、重複性好、可減少或彌補觀察者的主觀性差異。形態計量已套用於臨床病理診斷工作,包括非腫瘤病變與腫瘤病變。國內對非腫瘤性病變的研究已涉及到動脈粥樣硬化、肝硬變、前列腺肥大、克汀病、胰腺炎及精索靜脈曲張等;而對腫瘤病變的研究則是形態計量學在臨床研究的重點,目前較集中於消化道、肝、膀胱、乳腺和肺等器官的腫瘤。此外,在疾病的發生過程中把形態計量參數與功能變化指標有機地結合,有利於探討疾病的發病機制;形態計量參數對腫瘤病變的治療效果及預後判斷的估計亦有參考價值。
在形態計量學的研究中,首先是對樣品質量要求較高,例如製片過程中組織的收縮、膨脹與擠壓、切片厚度與方向,特別是切片染色技術,染色是使組織或細胞各成分能染成不同色澤而便於識別,提高待測成分圖像的可測性及其內在組分的表達性,使待測成分的色彩和亮度明顯清晰地區別於它的背景。採用常規染色、特殊染色以及免疫組織化學染色,可對不同著色的成分及反應物作形態定量測定;利用免疫組織化學和原位雜交技術使病灶染色,再作形態定量測量。其次是要找出特徵結構參數或定量指標,可先檢測組織或細胞的各種可測參數或根據待測成分的形態特點設計一些參數,再用統計學方法篩選出有用的參數作定量測定。由於儀器昂貴,目前國內尚處在實驗研究階段,臨床上的廣泛套用尚有一定困難。形態計量技術與常規技術和其它新技術綜合研究方法的使用,具有較好的套用價值及效果。
隨著各種新儀器的問世和新技術方法的不斷建立與使用,石蠟切片技術也逐漸擴展、滲入許多新領域中,做為基礎技術提供有效的實驗或使用樣品。石蠟包埋組織切片還可用於細胞原位核酸分子雜交技術中,可對材料中被雜交的DNA分子進行定位、含量分析或觀察基因表達(mRNA)水平;聚合酶鏈式反應(PCR)技術可用於固定、石蠟包埋組織的DNA分析,使研究進入了分子水平,但在短期內這些技術尚不能做常規使用。

